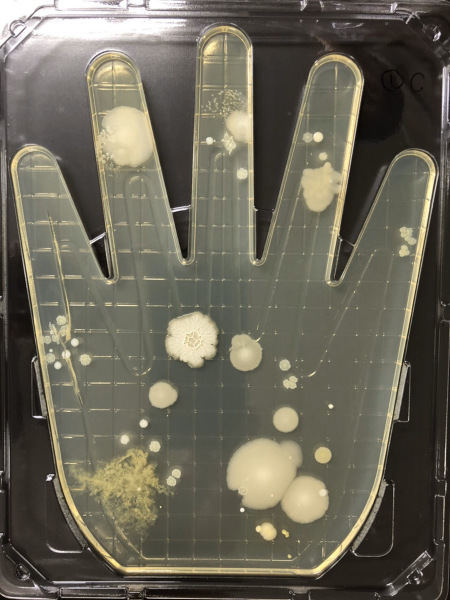

PC・スマホ
生活必需品となりつつあるスマホ。
素手でよく触ることから雑菌の温床になりやすく、ウイルスも付着している可能性が非常に高いのです。
中にはトイレに持ち込む人も!
素手でよく触ることから雑菌の温床になりやすく、ウイルスも付着している可能性が非常に高いのです。
中にはトイレに持ち込む人も!

文房具
ボールペン、修正テープなどは会社の備品として共有されている場合が多く、不特定多数の方が触れている状態となりがちです

本 雑誌
紙や本などは除菌アルコールなどを吹きかけて消毒しづらいわりに、多くの人に配布されています となると、手指の方に対策しなければなりません

本 雑誌
紙や本などは除菌アルコールなどを吹きかけて消毒しづらいわりに、多くの人に配布されています となると、手指の方に対策しなければなりません